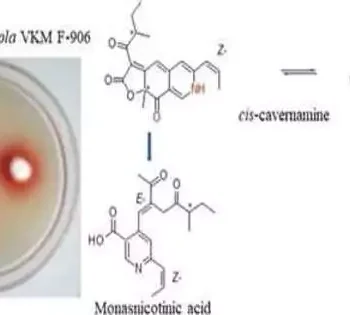

Urban communities overall are warming by 0.5 °C on normal each ten years — 29% quicker than in country regions — as per an article
Since urgent care centers and emergency rooms are frequently busy, patients may have to wait several hours before being seen, assessed, and treated. Because radiologists frequently examine x-rays for many
According to new research based on data from 18 countries, adults with better mental health are more likely to report having spent time as children playing in and around coastal
Skoltech specialists and their partners from the Pushchino Logical Place for Natural Exploration of RAS and Lomonosov Moscow State College found a never-before-seen substance with hostile to cancer properties in
According to new research co-authored by a UTM professor, children as young as five years old may exhibit signs of accent-based biases. Data revealed that children preferred teachers with a